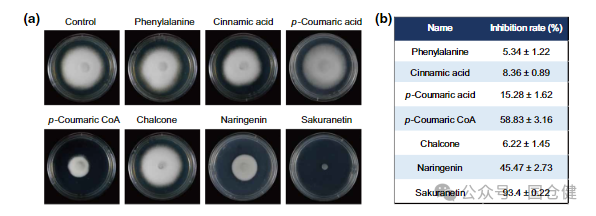
微信图片_20250107092940

近日,南京农业大学植物保护学院王一鸣教授研究组,在国际学术期刊New phytologist在线发表了题为Biosynthesis of sakuranetin regulated by OsMPK6
内容摘要
近日,南京农业大学植物保护学院王一鸣教授研究组,在国际学术期刊New phytologist在线发表了题为Biosynthesis of sakuranetin regulated by OsMPK6-OsWRKY67-OsNOMT cascade enhances resistance to false smut disease的研究论文,揭示了OsMPK6-OsWRKY67-OsNOMT信号级联调节樱花素生物合成参与水稻稻曲病抗性的新机制。植物源化合物樱花素对水稻稻曲病菌具有高效抑菌作用,为水稻稻曲病防治控提供了新的绿色防控手段。国仓建生物科技采用UPLC-MS/MS平台为项目提供了樱花素的定量检测服务。

首先,作者通过稻曲病菌侵染早期稻穗转录组及遗传学证据,发现了樱花素生物合成基因,在水稻对病原体抗性中发挥关键作用。通过体外平板拮抗实验筛选发现,樱花素相较于合成途径其他次级代谢产物在抑制稻曲菌丝生长、孢子萌发效果更加显著,是水稻抑制稻曲病侵染的核心次级代谢产物。
进一步研究表明,水稻响应稻曲病侵染,可快速激活MAPK信号途径。其中OsMPK6,一种丝裂原活化蛋白激酶,被OsMKK4激活后磷酸化WRKY转录因子OsWRKY67。同时,OsNOMT作为樱花素生物合成中的关键酶受到OsWRKY67直接调控。因此,在稻曲病侵染过程中,水稻通过激活OsMKK4-OsMPK6-OsWRKY67,调控OsNOMT表达,促进樱花素的合成,从而抑制稻曲病菌的侵染。

同时,研究建立了樱花素大肠杆菌合成体系,完成了樱花素的体外合成,降低了樱花素的施用成本。而喷施体外合成的樱花素可以显著抑制稻曲病菌对水稻的侵染。因此,本研究为水稻抗稻曲病提供了新的理论基础和化学防治手段。

南京农业大学为第一署名单位,南京农业大学植保学院博士生马金彪为论文第一作者。江苏省农科院刘永峰研究员,香港大学Clive Lo, 南京农业大学熊国胜教授、顾沁教授参与了该研究工作。研究得到国家重点研发计划和崖州湾种子实验室和种种集团联合揭榜挂帅项目的支持。